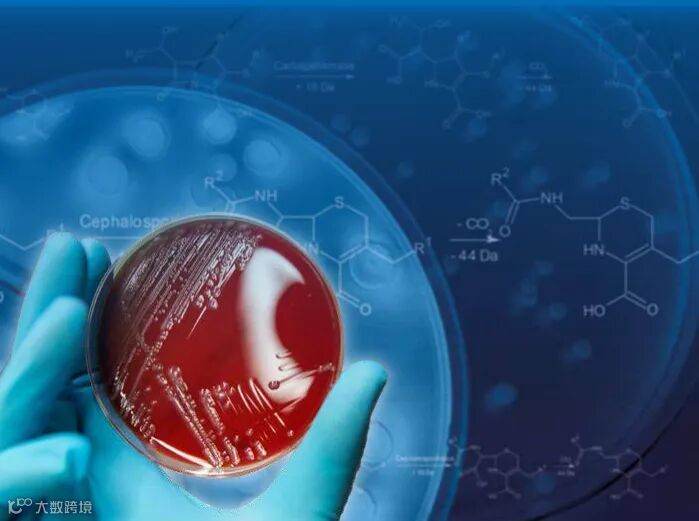
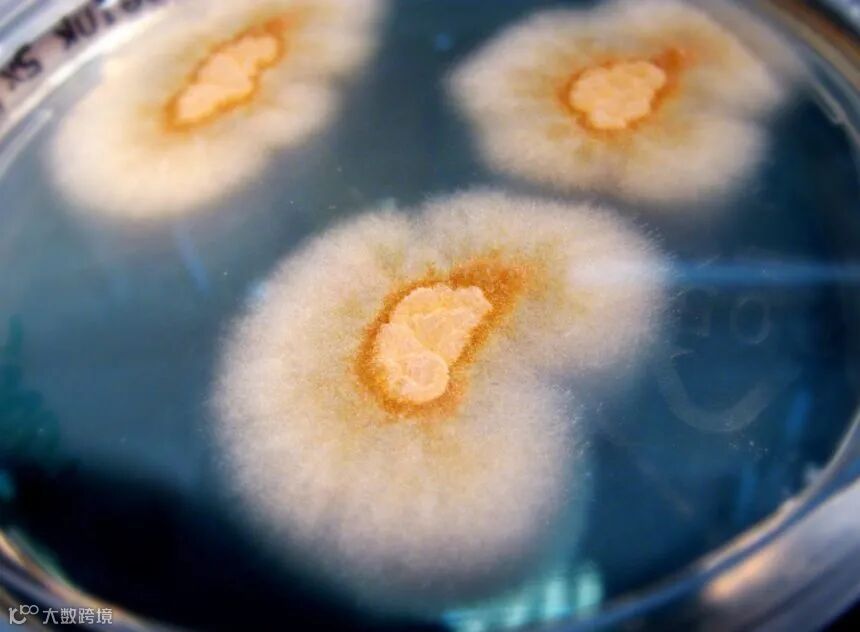

新版软件
MBT
Compass
系列

MALDI Biotyper使用最新版软件的必要性

随着布鲁克微生物质谱快速鉴定系统越来越普及地应用于临床用户实验室,快速、准确、高效,极大方便了临床标本的鉴定,从早期根植于windows7系统的MBT3.1及MBT IVD2.3软件到如今安装在windows10系统上的MBT Compass及MBT Compass IVD软件,也经历了版本的变更,新版本软件提供了更加丰富的功能模块使用,在满足日常鉴定的同时也提升了检验系统对科研的需求;下面就新版本MBT Compass及MBT Compass IVD新增加的功能做一些简单的介绍;


丝状真菌模块 MBT Filamentous Fungi Suite

包含丝状真菌模块及丝状真菌数据库,丝状真菌模块通过优化的算法确保丝状真菌最高的识别率;
丝状真菌库包含来自合作伙伴提供的工业、兽医和临床分离株的准确特征真菌菌株的参考质谱图、循环测试菌株和来自ISO 9001认证菌株库分离株的菌株;

Filamentous Fungi
说明:MBT3.1丝状真菌数据库目前支持更新到V4版本,MBT Compass支持最新V7版本及后续版本的更新;MBT3.1不支持丝状真菌模块的安装及使用;



分枝杆菌模块 MBT Mycobacteria RUO Suite

包含分枝杆菌模块及分枝杆菌数据库,分枝杆菌模块通过优化的算法提供高度可靠和快速分枝杆菌鉴定,分枝杆菌数据库涵盖了目前已知的201种分枝杆菌中的182种分枝杆菌;

Mycobacteria

说明:MBT3.1目前支持分枝杆菌数据库的使用,但是不支持分枝杆菌模块的安装及使用;


血培养阳性标本直接鉴定模块
MBT Sepsityper Module (RUO)

此功能模块用于分析阳性血液培养标本,MBT Sepsityper模块允许在MBT Compass软件中将适当的样本定义为血液培养样本。定义为血液培养样本的样本在MBT Sepsityper软件中使用优化的方法进行处理,并使用自适应的得分阈值进行报告。当处理血液培养物样品时,混合培养物检测可以作为一种选择被激活,结果以直观易懂的界面显示;


Sepsityper Module
说明:MBT3.1不支持该模块的安装及使用;
MBT Compass IVD可以使用MBT Sepsityper IVD;


菌株分型模块 MBT Subtyping Module

分型模块能够自动检测脆弱芽孢杆菌、肺炎克雷伯菌和金黄色葡萄球菌低于物种水平的特定特征;
此外,该模块允许密切相关的李斯特菌物种、伊丽莎白金氏菌物种和嵌合体/细胞内分枝杆菌复合体的分化;


说明:MBT3.1不支持该模块的安装及使用;MBT Compass IVD可以使用Subtyping IVD Module;


β-内酰胺酶引起的抗生素耐药性选择性检测
MBT STAR-BL Module

MBT STAR-BL IVD模块可在酶活性共孵育试验中快速、自动计算β-内酰胺类抗生素的水解速率;该软件计算与β-内酰胺抗生素水解形式对应的特征峰强度之和与非水解形式对应特征峰强度的总和之比,然后将结果标准化为水解(阳性)和非水解(阴性)对照菌株,以进行明确分类。该比率在易于理解的界面中显示为分值;

STAR-BL Module
说明:MBT3.1不支持该模块的安装及使用;
MBT Compass IVD可以使用MBT START-BL IVD Module;



一次性靶盘使用 MBT Biotarget 96 (RUO)

含独立条码的 96 孔一次性靶板 MBT Biotarget 96,搭配Adapter,无需清洁,用完即扔。


MALDI Biotyper 硬件部分的升级

工作站及操作系统,也是必不可少的部分:
硬件是否跟得上直接影响到鉴定速度的快慢,早期的工作站为HPZ420 workstation,随着机械硬盘硬件的老化,系统数据日益增多,已经逐渐对我们的日常鉴定或多或少产生了一些影响。比如下图:
针对HPZ420+MBT3.1+MBT IVD2.3用户,我们通过更换整个工作站电脑的方式,来升级到MBT Compass +MBT Compass IVD,新工作站电脑内包含一块系统固态硬盘和两块机械数据硬盘,大大提升软件使用流畅度,标本鉴定速度,以及数据安全性;
针对HPZ440+MBT3.1+MBT IVD2.3用户,我们通过安装windows10系统升级固态硬盘,升级到最新的MBT Compass + MBT Compass IVD;


Summary

旧版本的鉴定软件逐渐满足不了使用的要求,主要体现在以下几个方面:
1, 不支持最新数据库升级及后续数据库的升级;
2, 不支持最新的操作系统windows10;
3, 不支持分枝杆菌、丝状真菌鉴定功能模块的安装及使用;
4, 不支持其他科研功能模块的安装及使用;
5, 不支持一次性靶盘的使用;
6, 不支持硬盘数据定时冗余备份;
随着使用年限的增长,操作软件卡顿、鉴定速度下降、科研功能不完善等问题逐渐出现,而与日俱增的科研需求也与老旧软件格格不入,因此对老旧版本的升级迫在眉睫!




布鲁克(北京)科技有限公司
地址:北京市海淀区西小口路 66 号
中关村东升科技园
客户服务电话:400 810 1099
https://www.bruker.com